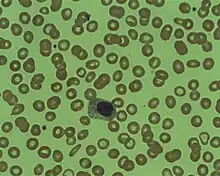

Myélémie
Un myélocyte sur un frottis sanguin, témoin d'une myélémie.
La myélémie est le passage dans le sang de précurseurs des granulocytes[1], comme des myélocytes et des métamyélocytes, ou plus rarement des promyélocytes et des myéloblastes (précurseurs encore plus jeunes).
Ces précurseurs proviennent de lieux de production de l'hématopoièse, comme la moelle osseuse.
La myélémie peut être équilibrée si elle est composée majoritairement de précurseurs les plus évolués (métamyélocytes et myélocytes) ou bien être déséquilibrée sinon.
Parmi les causes classiques de myélémie, on retrouve la leucémie myéloïde chronique et certains types de leucémies aigües myéloïdes[2].
Notes et références
- ↑ « Dictionnaire de l'Académie Nationale de Médecine » (consulté le )
- ↑ « Syndromes myéloprolifératifs », sur www.larevuedupraticien.fr (consulté le )
Liens externes
- Ressource relative à la santé :
- Portail de la médecine
- Portail de l’hématologie
Cet article est issu de Wikipedia. Le texte est sous licence Creative Commons – Attribution – Partage à l’identique. Des conditions supplémentaires peuvent s’appliquer aux fichiers multimédias.